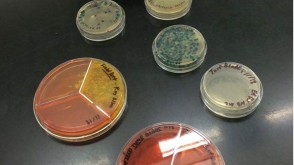
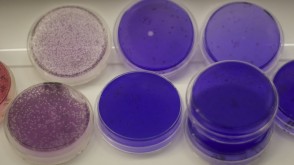

Microbiology is the study of small life forms such as bacteria, fungi, and viruses. Microbes can be both harmful and beneficial to health, the environment, and society. Many microbes are also common research organisms that are used in furthering our understanding of the fundamental properties of life.
About the Majors
The Microbiology major offers a foundation in biological principles with specialized courses in microbes (bacteria, viruses, fungi), immunology, and molecular genetics. As a Microbiology major you learn to identify, alter, or manage the a diverse range of microbes to benefit the larger world around us.
The Microbiology major at OWU has been described by professors at other universities as "an unusually excellent microbiology education." The major provides good preparation for medical school and careers in biomedical and industrial research.
Microbiology Bachelor of Science
The Bachelor of Science (B.S.) in Microbiology degree provides strong background in Microbiology with more diverse training in the natural sciences by requiring additional courses in Chemistry, Physics, and Math. It is primarily intended for students planning to pursue graduate school in Microbiology or medical school. See the requirements and courses.
Microbiology Bachelor of Arts
The Bachelor of Arts (B.A.) in Microbiology degree is designed for students interested in careers in microbiology, life sciences, and environmental sciences. Students also may pursue advanced degrees in medicine or other healthcare-related fields. Students who plan graduate study in Microbiology should pursue the B.S. degree at OWU. See the requirements and courses.
OWU also offers a minor in Microbiology.
Second Majors
The Microbiology major may not be combined with any other major or minor offered in the Biological Sciences. Some Microbiology B.S. students also major in Pre-Medicine. Some Microbiology B.A. students have chosen to also major in a second field that matches their interests, such as Music or Public Health.
Popular Minors for Microbiology Students